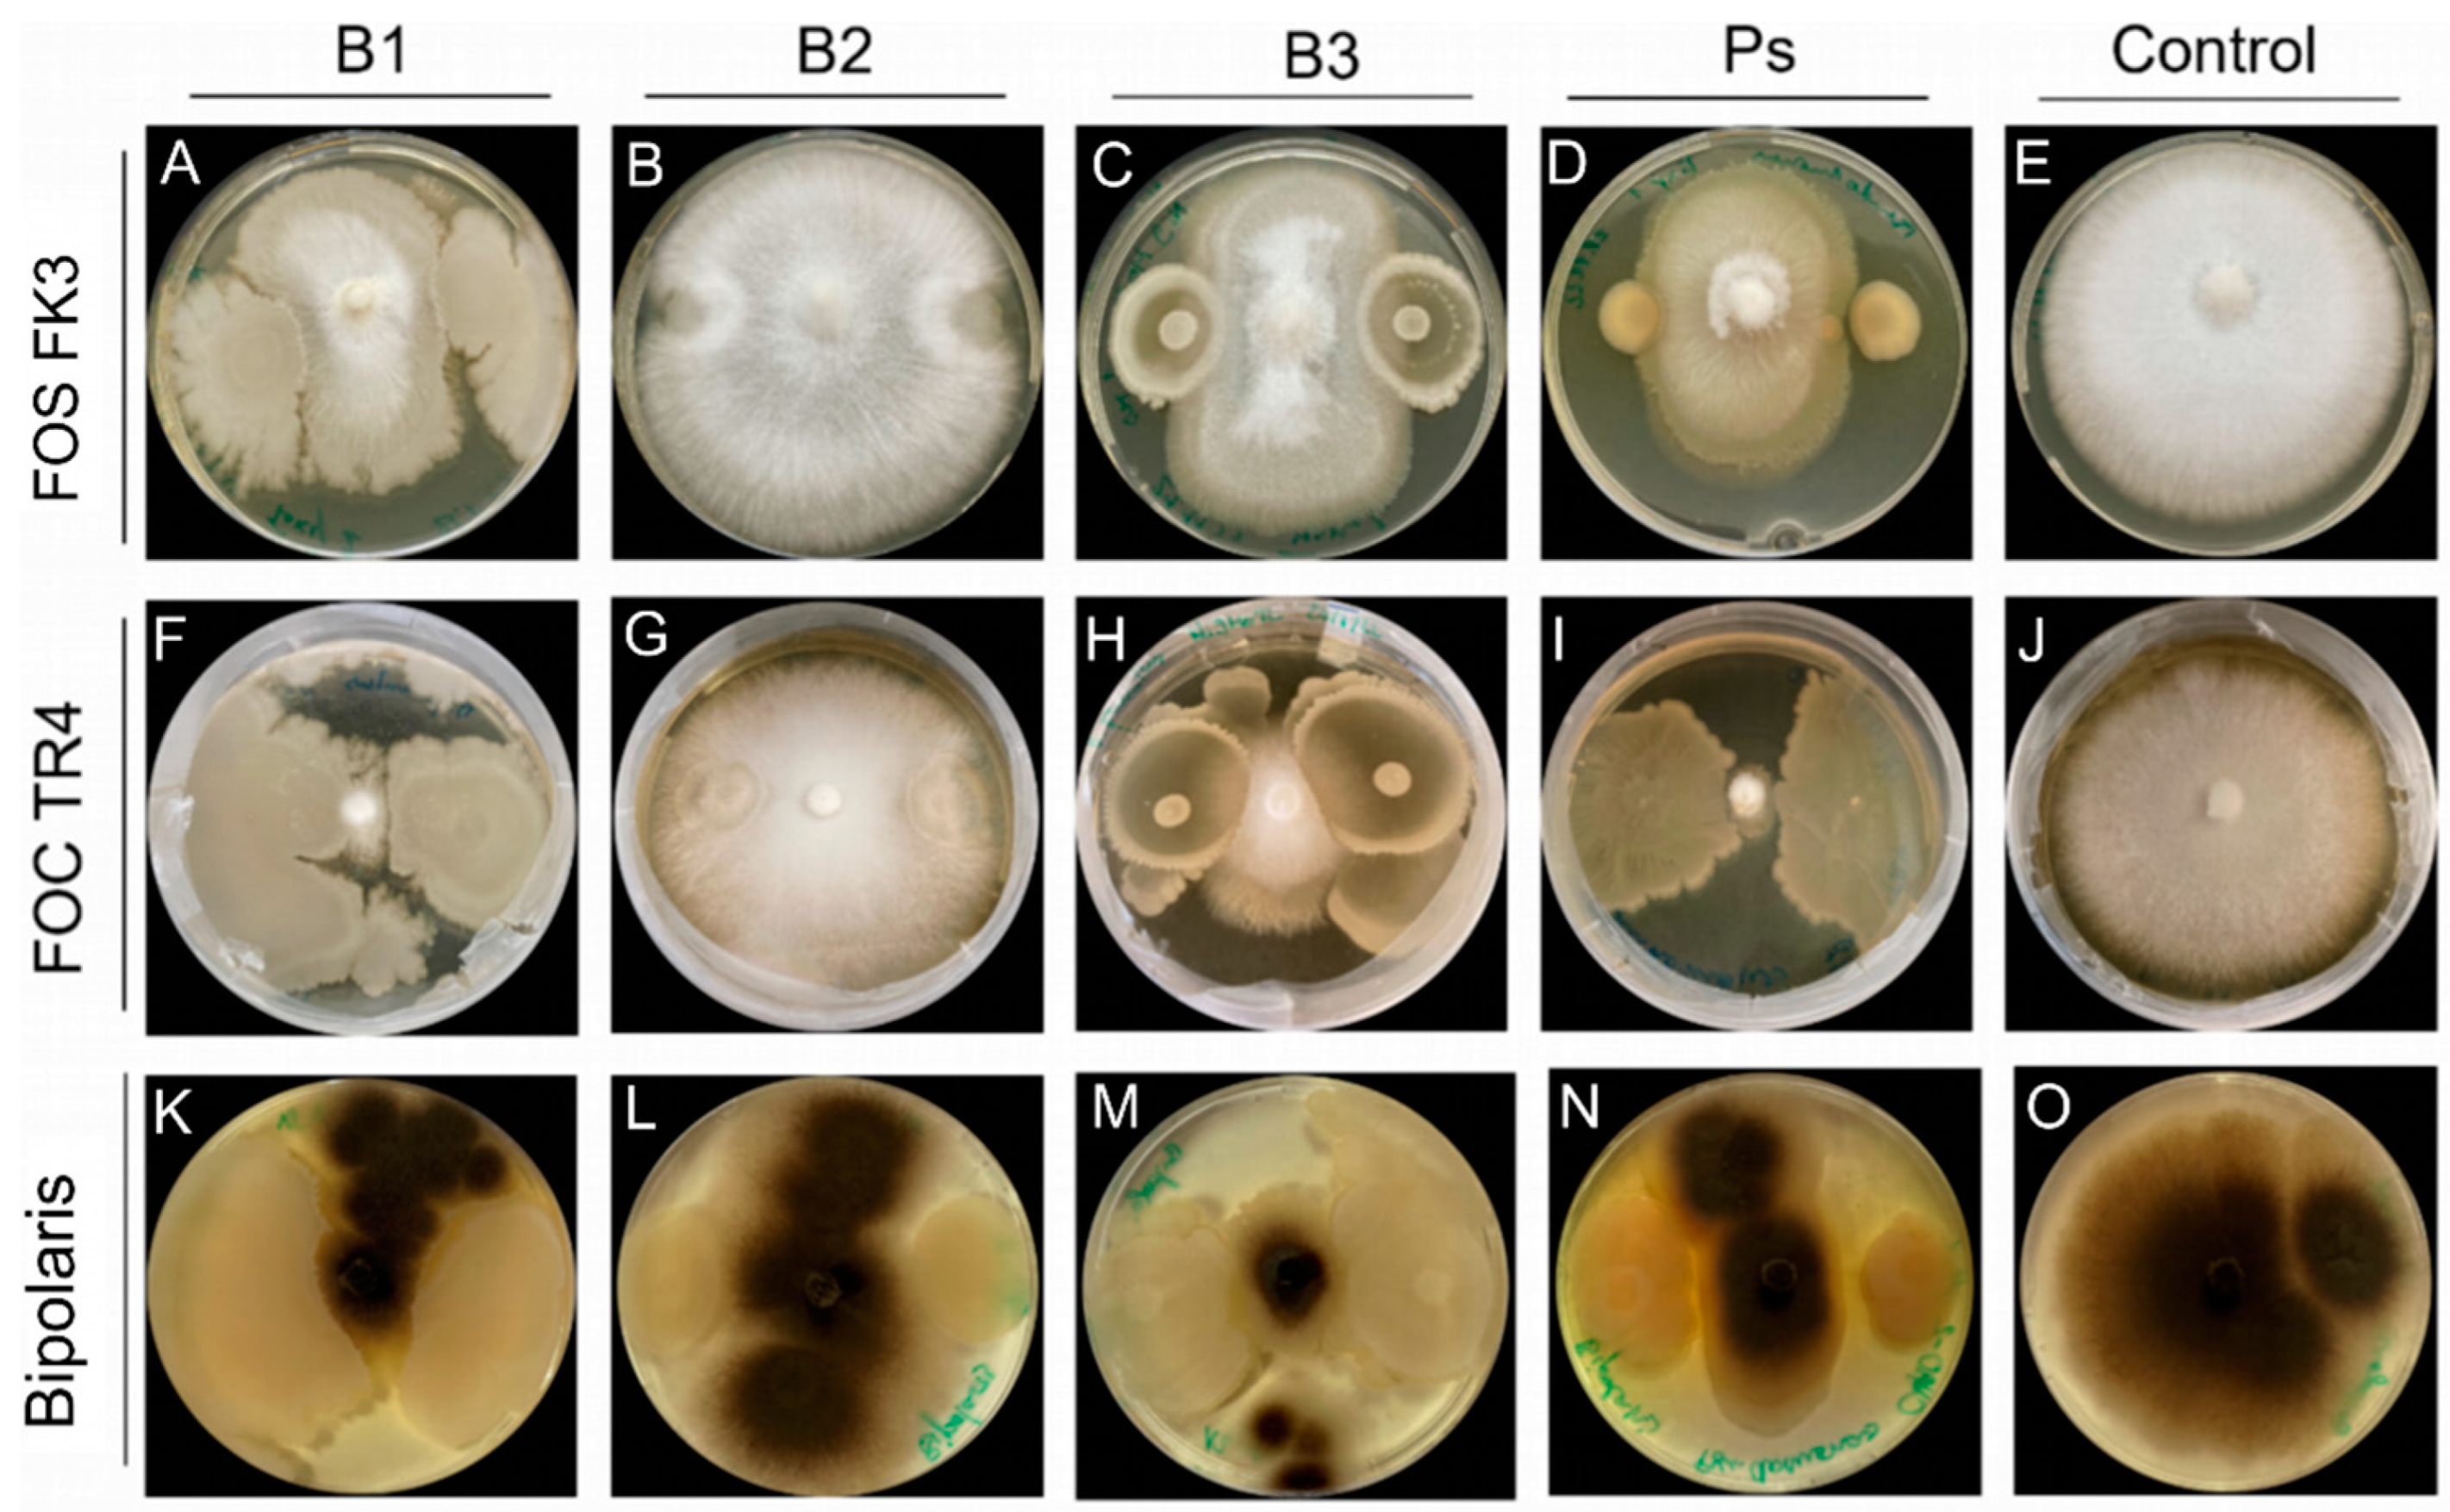

Role of Bacillus spp. Plant Growth Promoting Properties in Mitigating Biotic and Abiotic Stresses in Lowland Rice (Oryza sativa L.)
Abstract
:1. Introduction
2. Materials and Methods
2.1. Microorganisms
2.2. Plant Growth Conditions
2.3. Bacillus Inoculation
2.4. Bipolaris Oryzae Inoculation
2.5. Scoring of Disease Symptoms
2.6. Plant Harvest and Biomass Determination
2.7. Detection of Siderophores
2.8. Measurement of Indole Compounds
2.9. ACC Deaminase Activity
2.10. HCN Production Assay
2.11. Zinc Solubilization Assay
2.12. Phosphate Solubilization Assay
2.13. In Vitro Antifungal Activity
2.14. Data Analysis
3. Results
3.1. Effect of Bacillus spp. on Brown Spot Disease
3.2. HCN Production
3.3. Antifungal Activity
3.4. Effects of Bacillus spp. on Plant Growth
3.5. Siderophore Production
3.6. Auxin Production
3.7. ACC Deaminase Activity
3.8. Zinc and Phosphate Solubilization
4. Discussion
5. Conclusions
Supplementary Materials
Author Contributions
Funding
Data Availability Statement
Acknowledgments
Conflicts of Interest
References
- Dimkpa, C.; Weinand, T.; Asch, F. Plant-rhizobacteria interactions alleviate abiotic stress conditions. Plant Cell Environ. 2009, 32, 1682–1694. [Google Scholar] [CrossRef]
- Glick, B.R. Plant Growth-Promoting Bacteria: Mechanisms and Applications. Scientifica 2012, 2012, 963401. [Google Scholar] [CrossRef]
- O’Callaghan, M.; Ballard, R.A.; Wright, D. Soil microbial inoculants for sustainable agriculture: Limitations and opportunities. Soil Use Manag. 2022, 38, 1340–1369. [Google Scholar] [CrossRef]
- Glick, B.R. Bacteria with ACC deaminase can promote plant growth and help to feed the world. Microbiol. Res. 2014, 169, 30–39. [Google Scholar] [CrossRef]
- Spaepen, S.; Bossuyt, S.; Engelen, K.; Marchal, K.; Vanderleyden, J. Phenotypical and molecular responses of A rabidopsis thaliana roots as a result of inoculation with the auxin-producing bacterium Azospirillum brasilense. New Phytol. 2013, 201, 850–861. [Google Scholar] [CrossRef] [PubMed]
- Vacheron, J.; Desbrosses, G.; Bouffaud, M.-L.; Touraine, B.; Moënne-Loccoz, Y.; Muller, D.; Legendre, L.; Wisniewski-Dyé, F.; Prigent-Combaret, C. Plant growth-promoting rhizobacteria and root system functioning. Front. Plant Sci. 2013, 4, 356. [Google Scholar] [CrossRef] [PubMed]
- Padmanabhan, S.Y. The Great Bengal Famine. Annu. Rev. Phytopathol. 1973, 11, 11–24. [Google Scholar] [CrossRef]
- Barro, M.; Kassankogno, A.I.; Wonni, I.; Sérémé, D.; Somda, I.; Kaboré, H.K.; Béna, G.; Brugidou, C.; Tharreau, D.; Tollenaere, C. Spatiotemporal Survey of Multiple Rice Diseases in Irrigated Areas Compared to Rainfed Lowlands in the Western Burkina Faso. Plant Dis. 2021, 105, 3889–3899. [Google Scholar] [CrossRef] [PubMed]
- Becker, M.; Asch, F. Iron toxicity in rice—Conditions and management concepts. J. Plant Nutr. Soil Sci. 2005, 168, 558–573. [Google Scholar] [CrossRef]
- Padgham, J.; Sikora, R. Biological control potential and modes of action of Bacillus megaterium against Meloidogyne graminicola on rice. Crop. Prot. 2007, 26, 971–977. [Google Scholar] [CrossRef]
- Weinand, T.; Asch, J.; Asch, F. Effects of endophytic Bacillus spp. on accumulation and distribution of iron in the shoots of lowland rice grown under iron toxic conditions. J. Plant Nutr. Soil Sci. 2023, 186, 351–363. [Google Scholar] [CrossRef]
- Le, T.T.H.; Padgham, J.; Fornies, S.T.; Hartmann, J.; Asch, F. Rhizosphere bacteria Bacillus strains in mitigation of biotic and abiotic stresses in rice under oxic and anoxic conditions. In Proceedings of the Fourth Asian PGPR Conference 2015, Recent Trends in PGPR Research for Sustainable Crop Productivity, Hanoi, Vietnam, 3–6 May 2015. [Google Scholar]
- Yoshida, S.; Forno, D.A.; Cock, J. Laboratory Manual for Physiological Studies of Rice; The International Rice Research Institute: Manila, Philippines, 1976; Chapter 17; pp. 61–63. Available online: http://books.irri.org/9711040352_content.pdf (accessed on 28 July 2023).
- IRRI. Standard Evaluation System for Rice; International Rice Research Institute: Los Baños, Philippines, 2013. [Google Scholar]
- Louden, B.C.; Haarmann, D.; Lynne, A.M. Use of Blue Agar CAS Assay for Siderophore Detection. J. Microbiol. Biol. Educ. 2011, 12, 51–53. [Google Scholar] [CrossRef]
- Pérez-Miranda, S.; Cabirol, N.; George-Téllez, R.; Zamudio-Rivera, L.; Fernández, F. O-CAS, a fast and universal method for siderophore detection. J. Microbiol. Methods 2007, 70, 127–131. [Google Scholar] [CrossRef]
- Sarwar, M.; Arshad, M.; Martens, D.A.; Frankenberger, W.T. Tryptophan-dependent biosynthesis of auxins in soil. Plant Soil 1992, 147, 207–215. [Google Scholar] [CrossRef]
- Nascimento, F.X.; Glick, B.R.; Rossi, M.J. Isolation and characterization of novel soil- and plant-associated bacteria with multiple phytohormone-degrading activities using a targeted methodology. Access Microbiol. 2019, 1, e000053. [Google Scholar] [CrossRef]
- Dworkin, M.; Foster, J.W. Experiments with some microorganisms which utilize ethane and hydrogen. J. Bacteriol. 1958, 75, 592–603. [Google Scholar] [CrossRef]
- Lorck, H. Production of Hydrocyanic Acid by Bacteria. Physiol. Plant. 1948, 1, 142–146. [Google Scholar] [CrossRef]
- Gandhi, A.; Muralidharan, G. Assessment of zinc solubilizing potentiality of Acinetobacter sp. isolated from rice rhizosphere. Eur. J. Soil Biol. 2016, 76, 1–8. [Google Scholar] [CrossRef]
- Pikovskaya, R.; Pikovskaya, R.I. Mobilization of phosphorus in soil in connection with the vital activity of some microbial species. Microbiology 1948, 17, 362–370. [Google Scholar]
- Zygadlo, J.A.; Guzman, C.A.; Grosso, N.R. Antifungal Properties of the Leaf Oils of Tagetes minuta L. and T. Filifolia Lag. J. Essent. Oil Res. 1994, 6, 617–621. [Google Scholar] [CrossRef]
- Tsotetsi, T.; Nephali, L.; Malebe, M.; Tugizimana, F. Bacillus for Plant Growth Promotion and Stress Resilience: What Have We Learned? Plants 2022, 11, 2482. [Google Scholar] [CrossRef] [PubMed]
- Ahmad, F.; Ahmad, I.; Khan, M. Screening of free-living rhizospheric bacteria for their multiple plant growth promoting activities. Microbiol. Res. 2008, 163, 173–181. [Google Scholar] [CrossRef]
- Anwar, S.; Ali, B.; Sajid, I. Screening of Rhizospheric Actinomycetes for Various In-vitro and In-vivo Plant Growth Promoting (PGP) Traits and for Agroactive Compounds. Front. Microbiol. 2016, 7, 1334. [Google Scholar] [CrossRef] [PubMed]
- Rijavec, T.; Lapanje, A. Hydrogen Cyanide in the Rhizosphere: Not Suppressing Plant Pathogens, but Rather Regulating Availability of Phosphate. Front. Microbiol. 2016, 7, 1785. [Google Scholar] [CrossRef] [PubMed]
- Kirk, G.J.D.; Manwaring, H.R.; Ueda, Y.; Semwal, V.K.; Wissuwa, M. Below-ground plant–soil interactions affecting adaptations of rice to iron toxicity. Plant Cell Environ. 2021, 45, 705–718. [Google Scholar] [CrossRef]
- De Vleesschauwer, D.; Djavaheri, M.; Bakker, P.A.; Höfte, M. Pseudomonas fluorescens WCS374r-Induced Systemic Resistance in Rice against Magnaporthe oryzae Is Based on Pseudobactin-Mediated Priming for a Salicylic Acid-Repressible Multifaceted Defense Response. Plant Physiol. 2008, 148, 1996–2012. [Google Scholar] [CrossRef]
- Aznar, A.; Chen, N.W.; Thomine, S.; Dellagi, A. Immunity to plant pathogens and iron homeostasis. Plant Sci. 2015, 240, 90–97. [Google Scholar] [CrossRef] [PubMed]
- Weinberg, E.D. Nutritional immunity. Host’s attempt to withold iron from microbial invaders. JAMA 1975, 231, 39–41. [Google Scholar] [CrossRef] [PubMed]
- Herlihy, J.H.; Long, T.A.; McDowell, J.M. Iron homeostasis and plant immune responses: Recent insights and translational implications. J. Biol. Chem. 2020, 295, 13444–13457. [Google Scholar] [CrossRef]
- Sánchez-Sanuy, F.; Mateluna-Cuadra, R.; Tomita, K.; Okada, K.; Sacchi, G.A.; Campo, S.; Segundo, B.S. Iron Induces Resistance Against the Rice Blast Fungus Magnaporthe oryzae Through Potentiation of Immune Responses. Rice 2022, 15, 68. [Google Scholar] [CrossRef]
- Weinand, T.; Schierling, T.; Asch, J.; Kaufmann, B.; El-Hasan, A.; Voegele, R.T.; Asch, F. Bacillus-Mediated Cross-Protection against Iron Toxicity and Brown Spot Disease (Bipolaris oryzae) in Lowland Rice. In Towards Shifting Paradigms in Agriculture for a Healthy and Sustainable Future; Tropentag: Witzenhausen, Germany, 2021. [Google Scholar]
- Backer, R.; Rokem, J.S.; Ilangumaran, G.; Lamont, J.; Praslickova, D.; Ricci, E.; Subramanian, S.; Smith, D.L. Plant Growth-Promoting Rhizobacteria: Context, Mechanisms of Action, and Roadmap to Commercialization of Biostimulants for Sustainable Agriculture. Front. Plant Sci. 2018, 9, 1473. [Google Scholar] [CrossRef] [PubMed]
- Dubois, M.; Van den Broeck, L.; Inzé, D. The Pivotal Role of Ethylene in Plant Growth. Trends Plant Sci. 2018, 23, 311–323. [Google Scholar] [CrossRef]
- De Vleesschauwer, D.; Yang, Y.; Cruz, C.V.; Höfte, M. Abscisic Acid-Induced Resistance against the Brown Spot Pathogen Cochliobolus miyabeanus in Rice Involves MAP Kinase-Mediated Repression of Ethylene Signaling. Plant Physiol. 2010, 152, 2036–2052. [Google Scholar] [CrossRef] [PubMed]
- Sharma, R.; De Vleesschauwer, D.; Sharma, M.K.; Ronald, P.C. Recent Advances in Dissecting Stress-Regulatory Crosstalk in Rice. Mol. Plant 2013, 6, 250–260. [Google Scholar] [CrossRef] [PubMed]
- Hu, B.; Deng, F.; Chen, G.; Chen, X.; Gao, W.; Long, L.; Xia, J.; Chen, Z.-H. Evolution of Abscisic Acid Signaling for Stress Responses to Toxic Metals and Metalloids. Front. Plant Sci. 2020, 11, 909. [Google Scholar] [CrossRef]
- Shahzad, R.; Khan, A.L.; Bilal, S.; Waqas, M.; Kang, S.-M.; Lee, I.-J. Inoculation of abscisic acid-producing endophytic bacteria enhances salinity stress tolerance in Oryza sativa. Environ. Exp. Bot. 2017, 136, 68–77. [Google Scholar] [CrossRef]

| Scale (Affected Leaf Area) | |
|---|---|
| 1 | No incidence |
| 2 | Less than 1% |
| 3 | 1–3% |
| 4 | 4–5% |
| 5 | 11–15% |
| 6 | 16–25% |
| 7 | 26–50% |
| 8 | 51–75% |
| 9 | 76–100% |
| Total Indole Compounds µg mL−1 | |||
|---|---|---|---|
| 0 ppm Fe | 2.5 ppm Fe | 5.0 ppm Fe | |
| B. pumilus D7.4 | 6.43 ± 0.28 | 3.83 ± 0.15 | 7.07 ± 0.57 |
| B. megaterium | 33.88 ± 1.01 | 11.4 ± 0.55 | 15.82 ± 1.54 |
| B. pumilus Ni9MO12 | 28.69 ± 0.07 | 10.04 ± 0.74 | 8.49 ± 0.81 |
Disclaimer/Publisher’s Note: The statements, opinions and data contained in all publications are solely those of the individual author(s) and contributor(s) and not of MDPI and/or the editor(s). MDPI and/or the editor(s) disclaim responsibility for any injury to people or property resulting from any ideas, methods, instructions or products referred to in the content. |
© 2023 by the authors. Licensee MDPI, Basel, Switzerland. This article is an open access article distributed under the terms and conditions of the Creative Commons Attribution (CC BY) license (https://creativecommons.org/licenses/by/4.0/).
Share and Cite
Weinand, T.; El-Hasan, A.; Asch, F. Role of Bacillus spp. Plant Growth Promoting Properties in Mitigating Biotic and Abiotic Stresses in Lowland Rice (Oryza sativa L.). Microorganisms 2023, 11, 2327. https://doi.org/10.3390/microorganisms11092327
Weinand T, El-Hasan A, Asch F. Role of Bacillus spp. Plant Growth Promoting Properties in Mitigating Biotic and Abiotic Stresses in Lowland Rice (Oryza sativa L.). Microorganisms. 2023; 11(9):2327. https://doi.org/10.3390/microorganisms11092327
Chicago/Turabian StyleWeinand, Tanja, Abbas El-Hasan, and Folkard Asch. 2023. "Role of Bacillus spp. Plant Growth Promoting Properties in Mitigating Biotic and Abiotic Stresses in Lowland Rice (Oryza sativa L.)" Microorganisms 11, no. 9: 2327. https://doi.org/10.3390/microorganisms11092327
APA StyleWeinand, T., El-Hasan, A., & Asch, F. (2023). Role of Bacillus spp. Plant Growth Promoting Properties in Mitigating Biotic and Abiotic Stresses in Lowland Rice (Oryza sativa L.). Microorganisms, 11(9), 2327. https://doi.org/10.3390/microorganisms11092327

